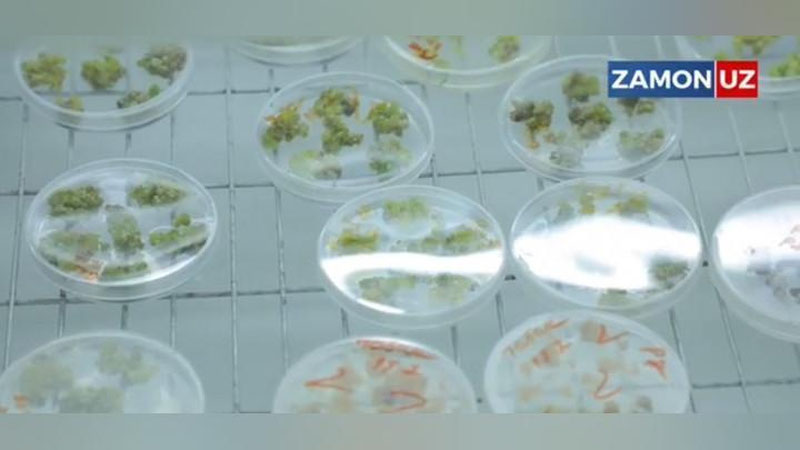

Руководитель отдела НИИ эпидемиологии и микробиологии им. Гамалеи Александр Бутенко прокомментировал информацию о создании узбекскими учеными съедобной помидор-вакцины от коронавируса.
В интервью радиостанции «Говорит Москва» он заявил, что технология «выращивание вакцин растительного происхождения имеет основания быть». При этом специалист отметил, что оценивать препарат сложно, «потому что Узбекистан не предоставил еще каких-то данных».
Говоря о таком типе вакцины, Бутенко отметил, что «это молекулярно-генетическая технология».
«Это возможный вариант, но нужны обязательно какие-то доказательства, результаты проверки препарата на лабораторных животных, чтобы вырабатывались антитела и был защитный эффект от коронавируса. Не знаю, есть ли в Узбекистане такие возможности, никогда не слышал об этом», — добавил он, заметив, что в России более востребованы вакцины в традиционной форме.
Ранее специалисты Центра геномики и биоинформатики Академии наук Узбекистана сообщили о создании помидор-вакцины. По их словам, у пациента появляются антитела после того, как он съедает «вакцинированный помидор».